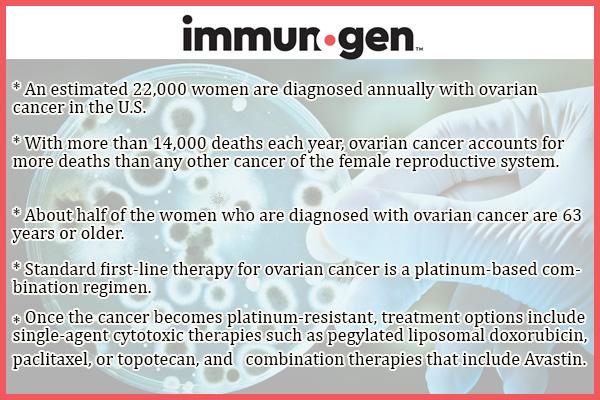
2013年癌症最新研究进展汇集,2019癌症研究治疗成果

在全球范围内,癌症是第二大死亡原因,仅次于心脏病。目前已知的癌症超过200种类型,在美国最常见的癌症是皮肤癌,而导致癌症死亡的主要原因是肺癌。

近日,知名财经网站RTT发文,对2019年值得关注的III期/关键性癌症临床研究进行了盘点:
1、Savolitinib

该药由和黄医药发现,正与阿斯利康合作开发,目前正处于III期临床研究SAVOIR中,评估治疗由c-MET癌症相关突变驱动的乳头状肾细胞癌(PRCC)患者的疗效和安全性。该药是一种高度选择性的MET酪氨酸激酶*制剂抑**。MET在肿瘤细胞增殖、存活和侵袭等方面发挥作用,因此是癌症治疗的一个很有吸引力的靶点。
Savolitinib是一种潜在首创的、高度选择性c-MET(间质上皮转化因子)受体酪氨酸激酶*制剂抑**,该酶已被证明在多种类型实体肿瘤中表现出功能异常。c-MET在肿瘤细胞增殖、存活和侵袭等方面发挥作用,因此是癌症治疗的一个很有吸引力的靶点。savolitinib被开发作为一种强效、高度选择性口服*制剂抑**,专门解决临床上其他选择性c-MET*制剂抑**治疗中所观察到的问题,比如肾*毒脏**性。
SAVOIR是在c-MET驱动的PRCC群体中开展的首个关键性临床研究,于2017年7月启动,预计2020年3月完成,该研究中将savolitinib与辉瑞已上市的RCC靶向抗癌药索坦(Sutent,通用名:sunitinib,舒尼替尼)进行比较。在II期临床研究中,savolitinib在这类患者中表现出了明确的疗效证据。
2、JCAR017

该药由新基旗下公司Juno研制,正开发用于侵袭性B细胞非霍奇金淋巴瘤的治疗。目前,新基正在开展III期临床研究TRANSFORM,在高危、二线、符合移植条件的复发性或难治性侵袭性B细胞非霍奇金淋巴瘤成人患者中,将JCAR017与标准护理进行比较。该研究于2018年10月启动,预计2022年10月完成。
JCAR017是一种针对CD19抗原、以4-1BB为共刺激区的CAR-T细胞疗法,CD4+和CD8+CAR-T细胞按照1:1比例回输。该药代表了目前在复发性和/或难治性弥漫性大B细胞淋巴瘤(DLBCL)治疗领域中潜在的同类最优(best-in-class)的CD19定向CAR-T疗法。
JCAR017与诺华的Kymriah和吉利德Yescarta靶向的是同一个靶标,但是接受JCAR017治疗的患者在进行嵌合抗原受体转导之前,就预先将CD4细胞与CD8细胞进行了分离,经过分别转导的细胞随后以特定的比例重新回输给患者,比其他CAR-T疗法的安全数据要更好,比如细胞因子风暴的概率更低。
3、Multikine

该药是CEL-SCI公司的先导临床项目,这是一种免疫治疗药物,正在开发作为头颈部鳞状细胞癌患者的潜在一线新辅助疗法,以及用于HIV/HPV共感染者宫颈发育不良或肛周疣的治疗。
该药的头颈部鳞状细胞癌III期研究正在进行中,这是全球最大规模的头颈部癌症研究,其主要终点是Multikine治疗方案联合标准护理(SOC)与单用SOC相比总生存期提高10%。该研究入组的最后一例患者已在2016年9月接受治疗,预计将在不久后公布研究最终结果。
Multikine是一款白细胞介素注射制剂,通常在肿瘤周围和淋巴结附近注射,这些区域最有可能发生肿瘤转移和复发。该药是一种全新的免疫疗法,来自I期和II期研究及病理性数据表明,其抗肿瘤的效应源自于以下几个方面:(1)可能识别和结合癌细胞上的多种不同抗原(或受体),可以直接影响或杀死癌细胞;(2)可能向免疫系统产生抗肿瘤的免疫反应信号,使其余的癌细胞更容易受到放疗和化疗的影响。
4、trastuzumab deruxtecan(DS-8201)

该药由卫材开发,正在一项III期临床研究DESTINY-Breast04中,评估治疗既往已接受标准化疗的HER2低表达、不可切除性和/或转移性乳腺癌患者。该研究已于本月启动,旨在包括但不限于北美、西欧和亚洲在内的约160个地区招募540例患者。另外,卫材也正在开展另2项全球性III期临床研究(DESTINY-Breast03和DESTINY-Breast02),评估该药治疗既往已接受治疗的HER2阳性不可切除性和/或转移性乳腺癌的潜力。
该药是一种抗体药物偶联物(ADC),通过一种4肽链接子将靶向HER2的人源化单克隆抗体trastuzumab(曲妥珠单抗)与一种新型拓扑异构酶1*制剂抑**exatecan衍生物(DX-8951衍生物,DXd)链接在一起,可靶向递送细胞毒制剂至癌细胞内,与通常的化疗相比,可减少细胞毒制剂的全身暴露。
乳腺癌是女性中最常见癌症类型和癌症死亡原因,大约20%为HER2阳性,其余80%被归为HER2阴性。HER2是在某些癌细胞表面表达的一种酪氨酸激酶受体促生长蛋白,与病情进展和不良预后相关。目前,HER2靶向疗法已在HER2阳性转移性乳腺癌治疗方面取得巨大成功。而归为HER2阴性的乳腺癌中,仍有大约一半表达低水平HER2作为细胞表面抗原,对于这些HER2低表达(定义为IHC 2+/ISH-或IHC 1+)乳腺癌,还没有抗HER2疗法获批,并且没有靶向性治疗模式。
5、ripretinib (DCC-2618)

该药是Deciphera制药公司的先导抗癌药,这是一种pan-KIT/PDGFRα靶向激酶*制剂抑**,可抑制KIT的磷酸化,降低赘生肥大细胞中磷酸化(p)STAT5、pAKT和pERK1/2的表达。
目前,该公司正在开展一项关键性III期临床研究INVICTUS,评估ripretinib四线或多线治疗胃肠道间质瘤患者的疗效和安全性。该研究于2016年12月启动,顶线数据预计将在2019年年中报告。
此外,该公司正在开展另一项关键性III期研究INTRIGUE,该研究于2018年11月启动,正在评估ripretinib相对于辉瑞靶向抗癌药索坦(Sutent)二线治疗胃肠道间质瘤患者的疗效和安全性。
6、NiCord

该药是以色列干细胞治疗公司Gamida Cell的先导临床项目,这是一种创新的、通用的、骨髓移植解决方案,开发用于高危血液系统恶性肿瘤患者的治疗。目前,该公司正在开展一项III期临床研究,在大约120例无匹配供体的患者中,评估NiCord相对于标准脐带血用于异基因造血干细胞(骨髓)移植的疗效和安全性。该研究预计将在2019年底完成患者入组,预计2020年上半年公布最新数据。
对于很多高风险血液癌症患者来说,骨髓移植是目前唯一可行的治疗方法,但前提是能够找到与患者完全匹配的捐献者,这并非易事。脐带血含有干细胞,可用于治疗疾病,其最大优势在于这些细胞都很“年幼”,因而不需要完全的组织相容性,但每份脐带血中干细胞数量并不多。
NiCord采用Gamida 独创的NAM平台技术开发,是一种将脐带血中的细胞在体外培养增殖获得的细胞移植物,其中含有丰富的干细胞、祖细胞和调节免疫功能的髓样树突状细胞。NAM技术克服了脐带血干细胞数量不足方面的局限性,可大幅增加其中干细胞数量,提升临床表现能力。
7、mirvetuximab soravtansine(IMGN853)
该药由ImmunoGen公司研制,是第一种靶向叶酸受体α(FRα)的抗体药物偶联物,通过一条带电荷的、可切割二硫键将能够产生细胞毒性的DM4分子和人源化的抗FRa抗体偶联起来。当该药与FRα结合之后,能够被细胞内化,从而让该药携带的细胞毒性分子可以切割释放,抑制肿瘤细胞的有丝分裂。
FRα是一种在卵巢癌中过度表达的蛋白质,在大部分(80-96%)上皮性卵巢癌呈持续高水平表达,而在正常卵巢上皮中并没有表达,因此成为了一个很有吸引力的治疗靶点。
目前,ImmunoGen公司正在开展III期临床研究FORWARD,评估该药作为一种单药疗法,治疗铂耐药卵巢癌的疗效和安全性。该研究的顶线结果预计在2019年上半年公布。
8、Tyvyt(信迪利单抗)

Tyvyt(信迪利单抗,商品名:达伯舒)是信达生物开发的一款创新肿瘤学药物,这是一种PD-1肿瘤免疫疗法,于2018年12月底获得中国国家药品监督管理局(NMPA)批准,治疗复发性或难治性经典霍奇金淋巴瘤(cHL)患者。在中国,Tyvyt由信达生物和礼来共同开发。
目前,信达生物正在开展III期临床研究ORIENT-16,评估Tyvyt联合卡培他滨和奥沙利铂作为一种一线疗法,用于晚期、复发性或转移性胃癌或胃食管交界腺癌患者的治疗。该研究计划招募650例患者,首例患者在最近接受了治疗。
9、alpelisib(BYL719)

该药由诺华开发,目前正处于一项III期临床研究SOLAR-1中,评估治疗接受芳香酶*制剂抑**(联用或不联用一种CDK4/6*制剂抑**)治疗期间或治疗后病情进展、携带PIK3CA突变、HR+/HER2-晚期或转移性乳腺癌绝经后女性患者,主要目的是评估alpelisib与氟维司群联合疗法相对于氟维司群单药治疗是否能延长疾病无进展生存期(PFS),次要终点为总生存期(OS)。
该研究于2015年7月启动,预计在2020年4月完成。去年10月公布的结果显示,alpelisib与氟维司群联合治疗组中位PFS为11.0个月,而氟维司群单药组为5.7个月,数据具有统计学显著差异(p<0.001)。该PFS治疗受益在所有亚组中保持一致,与芳香酶*制剂抑**治疗是否联用CDK4/6*制剂抑**无关。在PIK3CA非突变患者中,BYL719+氟维司群联合用药的PFS改善作用不明显。
alpelisib是一种口服生物可利用α特异性PI3K*制剂抑**。在携带PIK3CA突变的乳腺癌细胞系中,该药已被证明能够抑制PI3K通路,并具有抗增殖作用。此外,在广泛类型的癌症中,与未携带PIK3CA突变的癌细胞系相比,携带该突变的癌细胞系对该药的敏感性更高。据估计,大约40%的HR+晚期乳腺癌患者携带PIK3CA突变,而PI3K通路是HR+晚期乳腺癌中最常见的与肿瘤进展相关的突变通路。
10、ipatasertib

该药是罗氏的一款候选药物,正处于III期临床研究Ipatunity-130,评估ipatasertib联合化疗药物紫杉醇治疗晚期三阴性乳腺癌和HR+/HER2-乳腺癌的疗效和安全性。该研究于2018年1月启动,预计将在2021年12月完成。
ipatasertib从Array公司授权获得,该药是AKT的一种ATP竞争性*制剂抑**。PI3K/AKT/mTOR通路在约40%的三阴性乳腺癌中被激活,该通路被认为是开发乳腺癌药物的一个很有吸引力的靶点。
11、vicinium(VB4-845)

该药由Sesen Bio公司开发,目前正在开展一项III期临床研究VISTA,用于治疗先前已接受过标准护理卡介苗(BCG)免疫治疗无效的高级别非肌肉浸润性膀胱癌患者(即BCG无应答者)。
本月初,该公司公布了VISTA研究的队列1和队列2的初步数据,来自队列3的疗效数据以及VISTA研究的次要终点预计在2019年年中公布。
vicinium是一种靶向上皮细胞粘附分子(EpCAM)的人源化scFv免疫毒素,由一种重组人源化抗EpCAM抗体scFv与绿脓杆菌外毒素A偶联而成,一旦结合癌细胞表达的EpCAM就会被内化至细胞质中,诱导细胞凋亡。
12、UGN-101

该药是UroGen制药公司临床推进最快的候选药物,用于治疗低级别上尿路上皮癌的治疗。该公司已成功完成III期临床研究,数据显示,完全缓解率(CR)为57%。该公司已在2018年12月向美国FDA提交了UGN-101的新药申请。
UGN-101是一种尿路上皮凝胶,有效成分为丝裂霉素。该药可通过标准的膀胱内导管滴注到患者的病灶处,UroGen公司的特殊配方在室温呈液态,但是在体温环境下凝结成半固态。这一特性能够保持滴注在病灶处药物的持续释放,让尿路组织能够长期暴露在丝裂霉素的作用之下,从而使用非手术方法治疗肿瘤。
如果获得批准,UGN-101将成为治疗低级别上尿路上皮癌的第一个非手术治疗药物。
文章参考来源:12 Phase III Cancer Clinical Trials Worth Monitoring